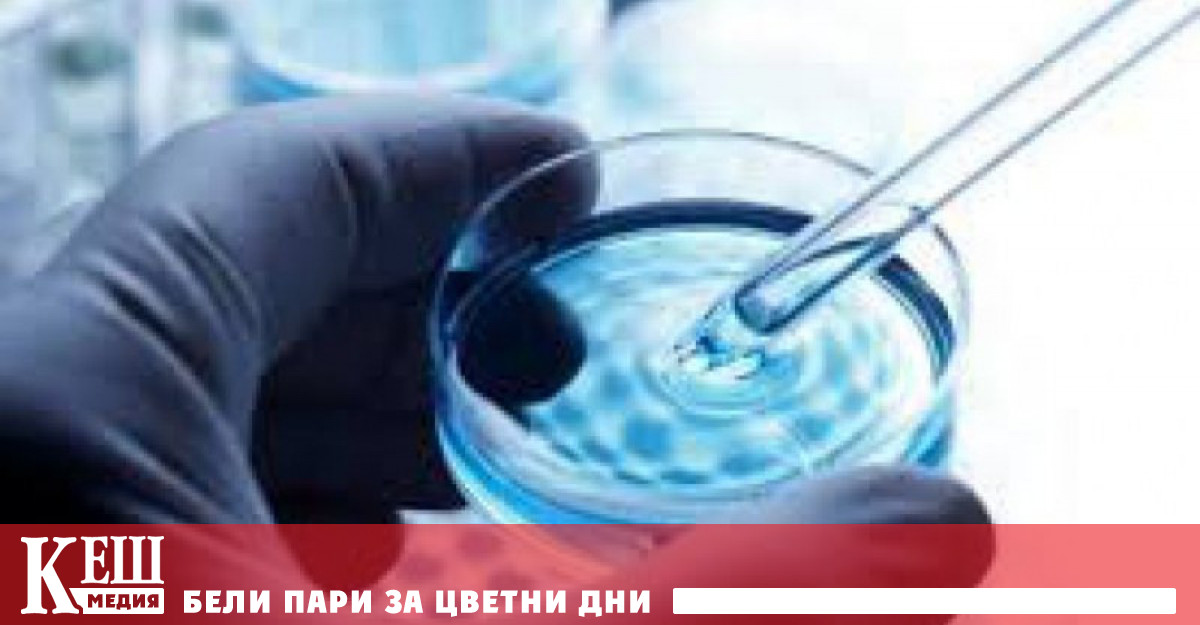
70-годишна жена роди първороден син

... и неговото семейство за новото попълнение. Младият татко сподели, че се чувства на седмото небе и благодари за подкрепата на всички свои близки и съотборници.
Първороден Син - Новини
Спас Делев изживя може би най щастливия момент в живота си
...... игра във всички 17 мача досега в елита, отбелязвайки три гола и шест асистенции с червено-черните. В „Надежда“ бившият национал дойде с трансфер от Лудогорец.
Огромна трагедия е застигнала моделката Златка Димитрова В подкаста Кухнята
...... кураж и воля да се справям с житейските удари.“ Въпреки болката, Златка показва завидна устойчивост и сила на духа, която вдъхновява мнозина. Автор: lupa.bg
Огромна трагедия е застигнала моделката Златка Димитрова В подкаста Кухнята
...... Златка показва завидна устойчивост и сила на духа, която вдъхновява мнозина. Инфо: lupa.bg Тагове: Златка Димитрова загуба бебе дете признание спонтанен аборт „Хелс Китчън“
Огромна трагедия е застигнала моделката Златка Димитрова В подкаста Кухнята
...... ми дава все повече кураж и воля да се справям с житейските удари.“Въпреки болката, Златка показва завидна устойчивост и сила на духа, която вдъхновява мнозина.
Златка Димитрова която е сред най старателните участници в отбора на
...... случвало, но съм ги минавала леко и винаги съм намирала изход. Това ми дава все повече кураж и воля, че се справям", откровена бе Златка.
Благата вест че е станала майка обяви самата Ивет Лалова
...... татко са снимали ръцете си заедно с ръчичката на новородения Тиаго. Точно като истинско щастливо семейство. Да им е честит сина на Ивет и Симоне! Автор:Лупа.бг
Благата вест че е станала майка обяви самата Ивет Лалова
...... татко са снимали ръцете си заедно с ръчичката на новородения Тиаго. Точно като истинско щастливо семейство. Да им е честит сина на Ивет и Симоне! Автор:Лупа.бг
Благата вест че е станала майка обяви самата Ивет Лалова
...... татко са снимали ръцете си заедно с ръчичката на новородения Тиаго. Точно като истинско щастливо семейство. Да им е честит сина на Ивет и Симоне! Автор:Лупа.бг
Най популярната и красива българка в САЩ моделката Рали Иванова се
...... САЩ през вече далечната 2006-а година. Известна е като българската Памела Андерсън. Преди време Ралица влезе в класация за стоте най-сексапилни жени на планетата.
Още една популярна българка стана майка за първи път през
...... цел... Човек идва на този свят с една основна мисия да стане ЧОВЕК и да създаде такъв... Време е моята мисия да започне". Изображение: https://www.instagram.com/lorenna_9/
Интервю за Фокус правнукът на лелята на Апостола Дона
...... така да си спомним отново за Левски. И никога да не го забравяме, да бъде едно знаме, по което да се движим в правилната посока.
Иван Живков Табаков проплака в ръцете на светилото в акушерство
...... семейство ден Благодарности и на д-р Златко Кироваков, както и на екипа на най-добрата Университетска болница " Дева Мария", написа Мария Табакова в своя Фейсбук профил.
Първата българка украсила корица на най популярното списание за мода в
...... щастие на младите родители, а на малкия Вихрен - безгрижно детство, смели мечти и много върхове за покоряване. Мило семейство, бъдете благословени! *Източник - “9 месеца“
70-годишна жена роди първороден син
...... Жителка на щат Гуджарат роди първото си дете на 70 години, съобщава Newsflare. Прочетете целия материал в cash.bg
Баща на първороден син стана нападателят на Монтана Сергей Георгиев
...... Алания, където отборът му е на зимен лагер. Щастливите родители благодарят на д-р Захари Николов и не целия екип в родилното отделение в Монтана. Честито!
Новата седмица донесе щастлива новина на най младия кмет в Мездренско
...... 47 см. Щастливите родители Нина Тодорова и Стоян Петров изказват благодарност към д-р Панова и нейния екип, довели на бял свят наследника на младото семейство.
Бившето гадже на Гери Дончева д р Костас Устабасидис се похвали
...... Гери не е честитила наследника на бившия си, защото двамата са във война и се съдят за хотел на морето, който плевенчанката заграби от гръка.
В навечерието на новогодишните празници 38 годишната певица Деси Слава стана майка за
...... да станеш баща! Благодаря на моята любима, че преди няколко часа ме дари със син. На 28.12.2017г. се роди нашето най-голямо богатство - Борис!"
Обещаващият ни млад боксьор Благой Найденов стана баща за първи
...... със син. На 28.12.2017г. се роди нашето най-голямо богатство - Борис!," написа Благой. Десислава вече има едно дете - Майки, който е на 17 години.
Националът по джудо и самбо Ивайло Иванов стана баща на
...... Щастливата баба Ирена днес цял ден черпи в родния град на европейския шампион Монтана, а тази вечер тръгва за София, за да види внука си.






&format=webp)